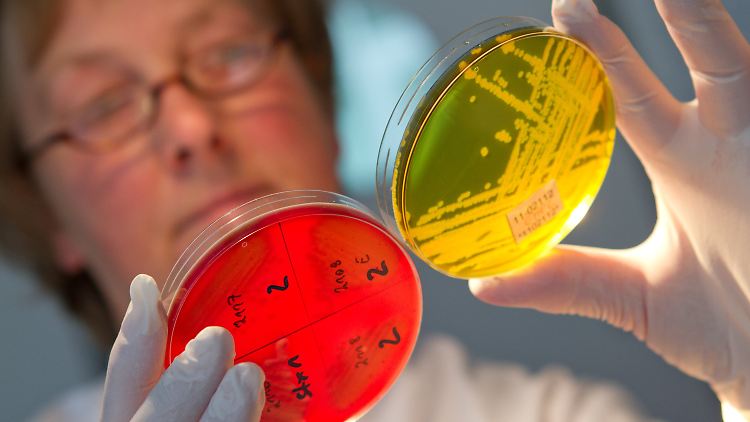
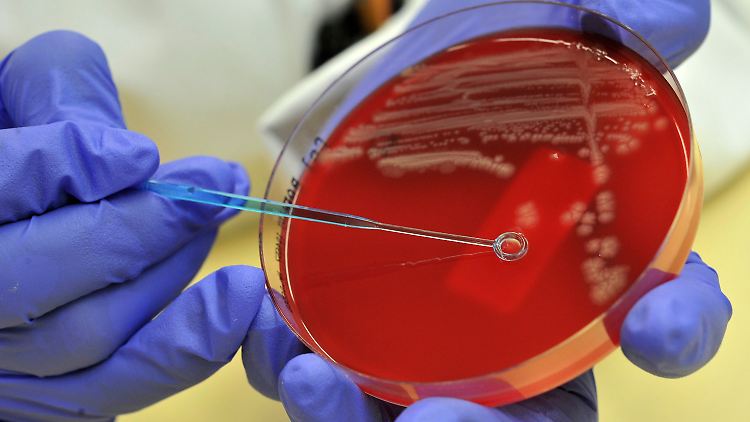

Gesundheitsgefährdungen
Nachrichten und Informationen auf einen Blick. Artikelsammlung von n-tv.de zum Thema Gesundheitsgefährdungen
ntv Nachrichtenfernsehen
ntv.de Dienste
Newsletter
Ich möchte gerne Nachrichten und redaktionelle Artikel von der n-tv Nachrichtenfernsehen GmbH per E-Mail erhalten.
Nicht mehr anzeigen